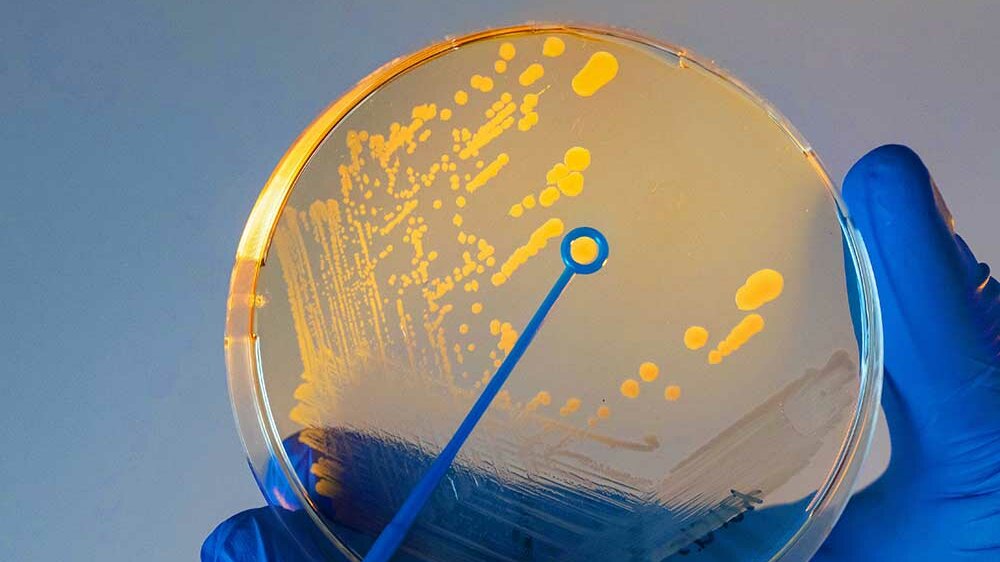
Cholerabakterien.jpg Cholerabakterien

Egal, um welche Viren es sich handelt, sie brauchen Wirte. Sind Viren auf Bakterien spezialisiert, nennt man sie Bakteriophagen, oder auch kurz Phagen. Sie sind die wahrscheinlich am häufigsten vorhandene Lebensform überhaupt. Doch wie vermehren sie sich innerhalb des Bakteriums und setzt sich dieses zur Wehr? Das untersuchten Forschende des Exzellenzclusters „Balance of the Microverse“ der Universität Jena.
Angriffsstrategien
Das Wechselspiel von Angriff und Verteidigung untersuchte die Forschungsgruppe an Cholera-Bakterien (Vibrio cholerae) und den Bakteriophagen VP882. Sobald die Phagen die Bakterien infizieren, gibt es zwei mögliche Wege zur Vermehrung. Entweder tarnen sich die Phagen und verstecken sich im Erbgut oder aber sie übernehmen die Kontrolle, vermehren sich in großer Zahl und zerstören anschließend das infizierte Bakterium. Welcher Weg gewählt wird, hängt von der sich in der Umgebung befindlichen Anzahl weiterer Wirtszellen ab.
Um dies herauszufinden, nutzen die Phagen das sogenannte „Quorum sensing“ der Bakterien aus. Hierbei geben Bakterien Signalmoleküle ab und geben sie in die Umgebung ab. Mittels hierfür spezifischer Rezeptoren nehmen sie wiederum die Konzentration dieser Moleküle auf und wissen dadurch, wie viele andere Bakterien in der Umgebung sind. „Der Trick der Phagen ist nun, dass sie diese chemische Kommunikation der Bakterien ,belauschen‘“, erläutert Prof. Kai Papenfort, Untersuchungsleiter.

Quorum Sensing
Im Experiment haben die Wissenschaftler und Wissenschaftlerinnen außerdem herausgefunden, was nach der erhaltenen Info des Quorum Sensing passiert. „Wir konnten beobachten, dass 99 Prozent der Bakterien innerhalb von 60 Minuten zerstört werden, in dieser Zeit übernehmen die Phagen die Kontrolle“, berichtet Dr. Marcel Sprenger, Erstautor der vorgelegten Publikation. Verantwortlich hierfür ist eine RNA: VpdS (VP882 phage derived sRNA). Sobald die Phagen das chemische Signal abgefangen haben, produzieren sie diese RNA in hohem Maß.
Um herauszufinden, welche Gene VpdS reguliert, infizierten die Forschenden die Bakterienkultur einmal mit VP882-Phagen und einmal mit genetisch modifizierten Phagen, die die sRNA nicht herstellen können. Dann beobachteten sie die Wechselwirkungen der RNA-Moleküle in den Bakterienkulturen zu diversen Zeitpunkten mittels einer „RNA interaction by litigation and sequencing“-Methode. Die Methode untersucht sowohl die Gene der Phagen als auch der Bakterien und liefert Informationen darüber, welche Gene aktiv sind und wie sie miteinander interagieren.
So fanden sie heraus, dass VpdS nicht nur die Phagen-Gene beeinflusst, sondern auch die der infizierten Bakterien – die Erklärung für die rasche Zerstörung der Bakterien. Es zeigte sich aber auch, dass manche Bakterien einen Gegenangriff starten, um die eigene Zerstörung zu verhindern. „Wir sehen hier Vorläufer des Immunsystems höherer Organismen. Die Bakterien haben zahlreiche Gene, die sie gegen Viren schützen“, erläutert Papenfort. Da es diese Gene auch in anderen Organismen gibt, gehen die Forschenden davon aus, dass in diesen Fällen RNA-Moleküle ebenfalls eine große Rolle spielen.
Quelle: idw
Artikel teilen